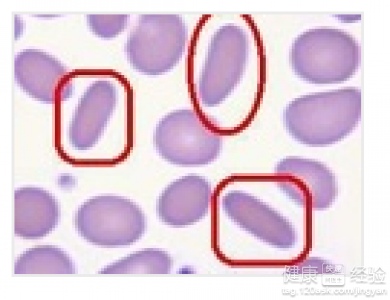
寶寶溶血性貧血的症狀有哪些

寶寶溶血性貧血的症狀有哪些
概 述
人的身體患的溶血性貧血這種疾病是指人們身體當中的紅細胞破壞加速的,而人們身體當中的骨髓造血功能代謝不足時引發的一種貧血疾病的,如果人們身體當中的骨髓能夠增加紅細胞的生成,溶血性貧血這種疾病用食療還有西藥中藥的方法都可以治療這種疾病的,還可以使用中西藥結合的方法治療這種疾病,溶血性貧血這種疾病是很少見的,溶血性貧血常伴有黃疸的。
步驟/方法:
1寶寶在患有急性溶血性貧血的時候會突發有寒戰,高熱的這些情況的,身體還會出現有乏力這些情況的,溶血性貧血由於紅細胞大量破壞的這種情況還會導致寶寶身體出現惡心,嘔吐的這些胃腸道症狀的。
2溶血性貧血這種疾病會分為有紅細胞內在缺陷所致溶血性貧血的,紅細胞本身存在著缺陷容易遭破壞,因此人們可以分為有先天性紅細胞缺陷所致溶血性貧血,還有獲得性紅細胞缺陷溶血性貧血兩種疾病的。
3溶血性貧血這種疾病可以進行血漿游離血紅蛋白測定這項檢查的,人們還可以進行血清結合珠蛋白測定來檢查溶血性貧血這種疾病的,血常規也可以診斷人的身體患有的溶血性貧血疾病的。

注意事項:
溶血性貧血這種疾病在吃藥的時候應該遵從醫生的囑咐,中醫治療溶血性貧血這種疾病是很有療效的,治療這種疾病的時候人們應該注意營養。
- 上一頁:寶寶腦積水是怎麼的
- 下一頁:寶寶地中海貧血的症狀有哪些
- 關於0到1歲知識
-
幼兒補鈣--蝦皮
幼兒補鈣--蝦皮
-
我的乙肝會傳染給孩子嗎
我的乙肝會傳染給孩子嗎
-
母乳喂養兒的生長發育最理想
母乳是嬰兒最天然、最優質的食物,其營養價值不容忽視。雖然年輕的
-
孕媽媽冬季要注意的情況
概 述 朋友懷孕7個多月的,她講是冬天分





